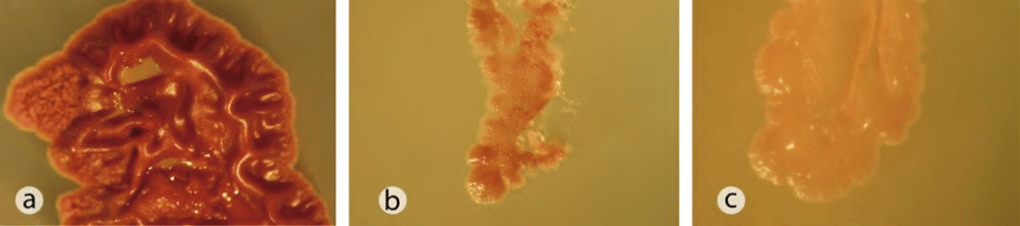

Ya que las plantas y los microorganismos solamente pueden adquirir el P como HPO4, necesitan de enzimas para romper las moléculas orgánicas y así liberar al P en esta forma. Estas enzimas son secretadas al ambiente por plantas y organismos para que realicen su función, ya sea en el suelo o en un ambiente acuático, y se conocen como exoenzimas o ecoenzimas; generalmente son específicas para cada tipo de molécula orgánica.
En el caso de las moléculas orgánicas que contienen P, las enzimas que rompen los ésteres de fosfato y los fosfonatos se llaman fosfatasas y fosfonatasas, respectivamente. Las fosfatasas las pueden producir la gran mayoría de los microorganismos y plantas, mientras que las fosfonatasas solamente las pueden producir algunos grupos específicos de bacterias y hongos. Una vez que el fósforo se ha liberado de la molécula orgánica, cualquier microorganismo o planta lo puede adquirir, y si esto no ocurre, al ser el ortofosfato tan reactivo, este será ocluido nuevamente.

Ilustración 1. Esquema simplificado de la dinámica del fósforo (P) en el suelo. Del lado izquierdo se observa la parte geoquímica y del derecho la parte biológica. En los suelos donde existe poco P en la roca (parte geoquímica), el almacén orgánico es muy importante (parte biológica) y ahí los microorganismos adquieren mayor importancia para que el P esté disponible (P en la solución del suelo). Se explican los procesos que ocurren (sobre las flechas). Modificado de Paul y Clark 1989.
La alternativa para enfrentar la crisis de Fósforo
Una alternativa para enfrentar la crisis futura del fósforo es reciclar el P que se encuentra en el suelo. Como se explicó anteriormente, una manera de reciclarlo es liberándolo, tanto de moléculas inorgánicas estables, como de moléculas orgánicas. Y para liberar al fósforo los microorganismos son la clave.
No cualquier microorganismo tiene la capacidad de producir todas las ecoenzimas y ácidos solubilizadores que se requieren para liberar el P de moléculas orgánicas o inorgánicas que lo retienen. Esta capacidad dependerá de los genes que los microbios tengan, lo cual les permitirá producir estos compuestos, y también dependerá de las condiciones adecuadas para la liberación del P. Por ejemplo, cuando los microorganismos están limitados por energía o por otros nutrientes, no pueden sintetizar estas sustancias debido a que su metabolismo tiene un déficit energético, así pues, las condiciones no serán adecuadas.
Afortunadamente, durante la larga evolución de los microorganismos en la historia de este planeta, éstos han desarrollado diferentes genes que les permiten acceder al P, ya que siempre ha sido un elemento escaso. Esta diversidad de genes microbianos se puede convertir en una herramienta muy útil para enfrentar a la carencia de fósforo que podría enfrentar la agricultura en el futuro.
Para ello, es necesario analizar la capacidad que tiene una comunidad microbiana dada para producir estas sustancias, lo que representaría su capacidad para liberar el P no disponible en el suelo. Así mismo es necesario identificar los genes que realizan estas funciones y cómo se expresan.
Con la selección de las especies microbianas que tengan las mejores capacidades, se podría implementar la producción de biofertilizantes que promuevan la liberación del P. Sin embargo, este tipo de investigación apenas se está desarrollando. En México se están estudiando estos microorganismos, una de las investigaciones más importantes es la de Cuatrociénegas, Coahuila. Es muy importante que la sociedad conozca la problemática del P. También es importante que se amplíe la investigación en esta área, para contar con herramientas que nos permitan asegurar la disponibilidad y accesibilidad de P a largo plazo, que sean distintas a la fertilización. La disponibilidad del fósforo de manera sostenible es indispensable para mantener la seguridad alimentaria en nuestro planeta.
Ilustración 2. Bacillus subtilis creciendo en medio lpdm (siglas en inglés de Low phosphorus defined medium) con diferentes fuentes de fósforo: a) fosfato de potasio (éster de fosfato), b) 2-aminoetil fosfonato, c) glifosato (fosfonato). Se aprecian las diferencias en el desarrollo de las colonias, dependiendo de la fuente de fósforo.
Referencias:
Tapia-Torres, Y., & Viladomat-Jasso, M. (2016). Fósforo: la nueva arista de la crisis global ambiental . Oikos, 22-24
